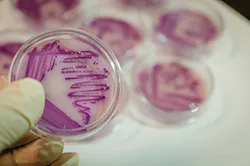
Sw1901 26 4 Sw1901 26 4

Innovative Filter Design Application Targeting E. Coli and Phosphorus Removal
High concentrations of Escherichia coli (E. coli) bacteria in urban stormwater and natural waters is a public health concern. Ingestion of E. coli can cause various diseases, such as gastroenteritis, urinary tract infections, and neonatal meningitis. Excess phosphorus in stormwater and natural waters is also a concern because high phosphorus levels cause algae blooms, inhibiting recreation and harming aquatic organisms. In the Shingle Creek watershed, a suburban-urban watershed in the Twin Cities metropolitan area of Minnesota, E. coli levels have been historically high (maximum 27,000 colony-forming units (cfu)/100 mL, average 1,091 cfu/100 mL, minimum 10 cfu/100 mL, with E. coli acute stand being 1,260 cfu/100 mL and chronic standard being 126 cfu/100 mL). Common sources of E. colito stormwater include pet and wildlife waste and sanitary sewer overflows or leakages. Phosphorus levels in the watershed are also high. Shingle Creek summer total phosphorus (TP) measurements for the past 10 years averaged 164 micrograms per liter (μg/L) and 151 μg/L at two different locations, with standard being 100 μg/L. Common sources of phosphorus include plant and leaf litter, soil particles, pet waste, and fertilizers. Because sources of both E. coli and phosphorus are diffuse, it is more practical to remove E. coli and phosphorus downstream than it is to reduce the sources of these pollutants.
Biochar has been effective in removing E. coli in the laboratory. Mohanty et al. (2014) performed a study in which E. coli-laden water was passed through a column of iron- and biochar-enhanced sand media. The study concluded that by adding 30% of biochar by volume to iron-enhanced sand, the media was able to remove 97% of E. coli on average. However, biochar’s effectiveness in removing E. coli from water has not been tested in the field. This study aimed to evaluate the feasibility and effectiveness of using iron- and biochar-enhanced sand filters in the field to remove both E. coli and phosphorus from surface water. Three field applications of this technology were investigated: a stormwater pond filter bench, a filter box through which creek flow was diverted, and a catch basin skimmer box insert.
Methods
Iron- and biochar-enhanced filters were constructed and installed in the Shingle Creek watershed using three different applications of this technology (Figure 1). First, three stormwater ponds were retrofitted with filter benches in the cities of Champlin, Crystal, and Minneapolis. Stormwater pond filter benches function by allowing water to flow through the filter when the pond level rises enough to overtop the bench. Perforated pipe exists below the filter and routes filtered water to the pond outlet. To partition the effect of biochar in the stormwater pond filter benches, the Crystal pond filter bench contained no biochar (only an iron-enhanced filter), and the Minneapolis (Olson) pond contained biochar only on the upstream half of the filter. The second application was a filter box that was installed at a waterfall in Shingle Creek in Minneapolis. The filter box consisted of a utility box filled with filter media underlaid by perforated pipe, as in the filter benches. Shingle Creek flow was diverted from the waterfall to the box and then back out to the stream. Third, two catch basin skimmer box inserts containing filter media were deployed in the cities of New Hope and Robbinsdale. Filter media filled about half of the skimmer box. Water draining into catch basins percolated through these filters and into storm sewer. All iron- and biochar-enhanced filters contained a mix of biochar and iron-enhanced sand at a ratio of 1:2 by volume. Biochar was placed in between two sand layers to prevent floating, clogging, and loss.
Pre- and post-treatment water samples were collected from the various filter applications and analyzed for total phosphorus (TP), dissolved phosphorus (dissolved-P), and E. coli. Stormwater ponds were sampled through the summer of 2017. Sampling at the Champlin stormwater pond took place every other week. Sampling at the Crystal Pond took place when the water level was high enough to flow through the filter, roughly monthly. The Minneapolis (Olson) pond had a leaking weir, and water level was too low to allow flow onto the filter bench, so no samples were collected in 2017. The creek flow diversion filter box was also monitored during the summer of 2017, and samples were taken roughly every other week. Catch basin skimmer box inserts were sampled during certain storm events.
Results and Discussion
E. coli Removal Efficiencies. All iron- and biochar-enhanced sand filter applications demonstrated E. coli removal efficiencies of 72% or greater (Figure 2). The Champlin stormwater pond, which was the only monitored stormwater pond containing a biochar-enhanced filter, had a 72% removal efficiency. The creek flow diversion filter box had a 93% removal efficiency. The two catch basin filter inserts had removal efficiencies of 73% and 93%, respectively. The Crystal stormwater pond filter bench, which served as a negative control and did not contain any biochar, had a 0% removal efficiency, indicating that the biochar and not something else in the filter bench is responsible for E. coli removal.
Figure 3 summarizes the E. coli sampling results of all sites. E. coli removal results were as expected. All sites containing biochar demonstrated removal of E. coli. As indicated, the Crystal pond bench does not contain any biochar for comparison purposes. The lab results indicated no removal compared to other BMPs. The flow diversion filter box has the most consistent results. Removal was seen on all sampled days. Although the stream does not contain a constant high level of E. coli, the filter box was still able to reduce the concentration further.
Crystal pond bench samples show no E. coli removal.
The exact mechanism of biochar E. coli removal is still unknown, but possible mechanisms include trapping and killing E. coli cells. The concern with trapping is that E. coli could establish colonies on the biochar surface and be released into water later. However, never was an outflow sample higher in E. coli concentration than an inflow sample, indicating that no E. coli colonies were established on the biochar media or no releases of E. coli took place.
Phosphorus Removal Efficiencies. Phosphorus removal efficiencies ranged from 0 to 81% (Figure 4). Figure 5 summarizs the TP from inflow and outflow at each device. In most cases, iron-enhanced sand is expected to remove phosphorus. However, at both catch basin sites, total phosphorus increased in outflow. It is possible that the media in catch basins bound phosphorus and other constituents (such as fluoride, sulfide, and organic matters) and became clogged, losing the ability to convey water. Preferential flow therefore bypassed the media matrix and did not get treated. This is not as plausible because E. coli did get reduced on the same days. Another possibility is the accumulated plant litters on the media surface. Additional phosphorus released from the broken-down leaves could get flushed out during the rainfall event, thus adding onto the total phosphorus in the outflow.
The rest of the devices had similar response. The flow diversion filter box still had the best results. This is because the filter box was the most controlled device. It received relatively consistent flow and it experienced the least mixing at outlet. At both ponds, phosphorus had reasonable reduction. Champlin had constant flow throughout the flowing season. But Crystal had a significant amount of dry period when water surface elevation was lower than filter bench and no flow was being treated. Mixing was seen at outlets of both pond filter benches when water level rose above the bench outlets after a major storm event. This could increase phosphorus concentration in the outflow samples.
Figures 6 and 7 summarize the dissolved-P reduction from all devices. Results were similar to TP reductions except for the catch basin sites. Catch basin skimmer boxes had no TP reduction in all samples, but dissolved-P was reduced in some samples. This was because iron-enhanced sand filter is designed to target dissolved phosphorus. Unfortunately, not enough water sample was collected on those days to measure both parameters.
Total suspended solids (TSS) was also monitored at the flow diversion filter box. An 83% average reduction was measured. This translates into 0.63 pounds per year. The amount of TSS removed was limited by flow rate and TSS inflow concentration. The average TSS inflow concentration measured during sampling time was 8.12 mg/L. This agrees with the long-term monitoring data for Shingle Creek, where 65% of measurements during flow season are between 0.5 and 15.5 mg/L.
Summary
The study results showed that biochar has very promising potential in removing E. coli from stormwater. The modification to the existing iron-enhanced sand not only provides additional benefit in the form of phosphorus removal, but also prevents biochar loss due to floatation. Further, all three types of field designs tested here can be useful in different scenarios. However, the mechanism of E. coli removal by biochar is still unclear and the longevity of iron- and biochar-enhanced sand filters in the field must still be determined. These knowledge gaps should be investigated now that this study has determined the great potential of biochar- and iron-enhanced sand filters in removing E. coli and phosphorus from stormwater.
Acknowledgement
Funding for this project was provided by the Minnesota Pollution Control Agency through a grant from the United States Environmental Protection Agency, Section 319 Nonpoint Source Management Fund, and by the Shingle Creek and West Mississippi Watershed Management Commissions. Dr. Andy Erickson, Dr. John Gulliver, and Dr. Beth Fisher from the University of Minnesota and Dr. Sanjay Mohanty from University of California Los Angeles provided insights and assistance to the project.
Reference
Mohanty, S.K., K.B. Cantrell, K.L. Nelson, and A.B. Boehm. 2014. “Efficacy of Biochar to Remove Escherichia coli from Stormwater Under Steady and Intermittent Flow.” Water Research 61: 288-296.